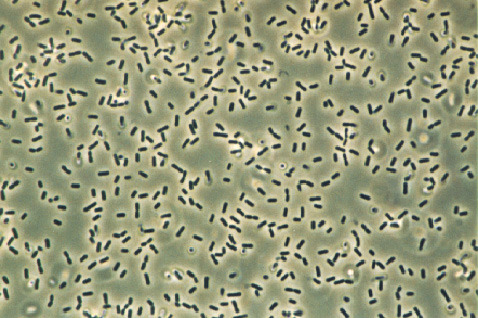
Bacillus_subtilis_%282%29.jpg

브라맛 #48 청국장
통일동산두부마을(파주)
통일동산두부마을(파주)
장단콩. 장단 지역에서 재배되는 콩으로 1969년 최초 작물시험자에서 인공교배를 통해 육성 보급된 장려품종 광교도 '장단백목'과 일본으로부터 도입종인 '육우 3호'와의 교배 육성종. 1970년 초부터 민통선 지역 개발로 통일 동산 및 통일촌 입주시점 장단 민북지역에 400헥타르의 재배면적을 확보하고 재배하기 시작한 콩이다.
현재 파주 명품콩으로 육성되어 파주 지역의 콩으로 만든 음식점 대부분은 이 파주장단콩으로 요리를 하고 있다. 오늘은 이 콩으로 만든 음식 중 내가 사랑한 나머지 그 구수한 냄새에 끌려 올 수밖에 없었던 집. 지역 생산 콩으로 만든 청국장으로 더욱 유명하다길래 찾아왔다. 무려 1박 2일 코스로 브롬톤 라이딩 총 133km를 달려서 말이지.

우선 식사 전후 액티비티
획고 369m, 거리 133.06km
월간 누적거리 228.01km
소모칼로리: 2670kcal
라이딩 러닝 타임: 7시간
주요 코스: 죽전 - 잠실탄합 - 안양합수부 - 행주대교 - 자유로 - 일산 - 파주 - 일산 - 신사(신분당선)
기온: 최고 9도, 최저 -1도, 출발온도 5도
날씨: 흐린 후 맑음
바람: 서풍 3~4ms
미세먼지: 보통, 초미세먼지: 보통, 자외선: 보통
복장: 지로 헬멧, PNS 동계용 비니, 스파이더 져지/슈즈, Rapha & FILA 동계용 팬츠/이너, 스카이시프트 고글, Rapha 라이트웨이트 재킷
작년 말 세일 기간에 미리 구입해 둔 라파의 이너용 빕숏을 입고 간다. 꽤 장거리라 엉덩이를 고려해서. 아직은 겨울이니 FILA 팬츠 이너용으로 레이어드. 그러나 이게 패착이었다. 달릴수록 빕숏과 팬츠는 궁합이 좋지 않아 흘러내리기 일쑤였고 달리면서 계속 바지 뒷춤을 움켜잡고 올려야 하는 웃지 못할 현실. 이래서 하프 빕보다는 빕숏이 나은 듯. 잠실 탄합까지는 어떻게든 달린 후 첫 번째 휴식. 미니 초코바 하나를 취하며 쉰다. 주변에서 연신 담배를 피워대는 인간들만 빼면 그럭저럭 괜찮은 휴식 포인트였다.

자 다시 달리기 시작한다. 바람은 역풍(똥풍). 어찌나 몸을 밀어재끼는지 기어비를 조정할 수밖에 없다. 연신 페달링 하면서도 가장 재미없는 구간인 여의도를 지나며 순간 생각했다. 그냥 집에 갈까? ㅋ. 하지만 맛집을 포기할 순 없다. 드디어 안양 합수부에 도착. 잠시 쉬자. 서편으로부터 불어오는 바람의 기세가 꺾일 일이 없어 보인다. 물결을 보시라. 바람이 밀어재 낀다. 이걸 그대로 온몸으로 이겨 내며 달려간다.

결국 몸이 힘들어한다. 계속 참고 달려내기엔 봉크가 올 지경. 하여 결국 선택했다. 한강변 편의점 별미 중 하나. 편. 의. 점. 자. 판. 기. 라. 면. 가양대교 아래 CU 편의점에서 4천 원대로 잠시 중간 보급한다. 라이딩 한지 두 시간째다. 계란을 풀어넣고 물 460ml에 살짝 덜 익은 듯한 상태에서 자리로 이동하는 순간 맛을 꽃피워내는 자판기 라면. 오늘도 꿀맛이다.


일산 자유로로 들어서기 전 네이버 지도앱은 내게 행주대교를 추천했다. 하지만 패착 중의 하나였다.
반포 잠수교를 넘어갈걸 그랬다. 길모 양도 안 좋을뿐더러 매우 지저분하다. 펑크가 날까 두려워하며 건넜다.

한강 동남부의 시간과 정신의 방 하남미사 직선 로드가 있다면, 한강 북서부엔 일산 자유료가 있다,. 끝없이 펼쳐지는 직선. 주변에 즐길 거리라곤 갈대밭과 한강 물밖엔 변화가 없는 길. 정말 혼자 가기엔 쓸쓸함 그 자체. 날이 따듯하면 그나마 참을 만 하지만 바람을 그대로 맞으며 달리기엔 브롬톤 라이딩으론 곤욕이다. 하지만 나는 자전거 라이딩을 사랑한다. 아니 즐거움 그 자체 아니던가. 꿋꿋이 이겨내고 간다. 드디어 일산 킨텍스에 도착. 오늘의 맛집 가이드 동네 브로와 함께 조인 후 맛집으로 이동한다.


사실 78km를 달리고는 너무 힘든 나머지 1박을 결정. 맛집 브로와 함께 저녁을 쉬었다. 다시 20여 킬로를 달려 파주의 아침. 드디어 이 맛집을 방문했다. 자 오늘의 브라맛집!!! 나의 애정하는 청국장 되시겠다.
운동 중 리커버리를 위한 오늘의 맛집 - 통일동산두부마을 (파주)

단체석을 포함해 대략 200여 석을 자랑하는 엄청난 규모의 매장. 일하는 서빙 직원만 여덟 분이 바쁘게 일손을 돌리며 오간다. 크게 부르지 않으면 들리지 않을 정도라 손짓 발짓도 간혹 필요할 수 있겠다.
'볏 짚이 상당히 중요한 역할을 해서 필요하단다. 구해오면 엄마가 청국장을 제대로 만들어 먹여주마'
나는 왜 청국장에 볏짚이 필요한지 의구심이 들어 검색해 보고 또 찾아보고 어머니께 다시 여쭈어 보았다. 청국장은 한국의 전통 발효식품 중 하나로, 주로 대두를 발효시켜 만드는 음식이다. 그렇다. 발효.
청국장을 만들려면 콩을 깨끗이 씻고, 물에 8시간 이상 충분히 불린 후, 냄비나 압력솥에 넣고 1시간~2시간 반을 푹 삶는다. 그리고 그대로 발효하면 안 되고 충분히 콩을 다시 식혀 물기를 빼주어야 한다.
물기가 충분히 빠지고 식었다면, 발효를 시작해야 하는데 콩을 용기에 담아 면포를 씌우고 37~42도에서 이틀, 길게는 사흘 정도 발효시킨다. 이때 가장 중요한 볏짚을 깔아주어야 하는데 볏짚에서 자라는 효모 바이러스인 바실러스 서브틸리스(Bacillus subtilis)라는 유익한 미생물이 번식하여 청국장의 맛과 향을 결정하는 중요한 역할을 하게 된다.
바실러스 서브틸리스?
바실러스 서브틸리스(Bacillus subtilis)는 마른 풀이나 볏짚에서 자라는 고초균으로 불리는 발효균이다. 적정 온도와 원활한 공기 순환이 중요한데, 잘 자라는 내열성균이자 호기성균에 속한다. 메주, 된장, 청국장, 간장을 만드는 데 역할을 하며, 청국장을 끓여도 150도까지 살아남을 만큼 산에도 강한 능력이 있다. 여기에 방점을 찍고 기억해 두시라. 이 균이 그 강하디 강한 산성의 위산을 이겨내고 대장까지 도달해 낸다. 그리하여 장이 좋지 않은 이들에게 항상 권하는 음식이 바로 청국장이다. 뿐만 니라 장 내 숙변의 분해를 돕고, 대장 운동을 촉진해 쾌변, 비만, 피부 개선에 꽤나 도움을 주는 음식이 바로 청국장 되시겠다.
발효가 끝난 청국장용 콩은 절구에 넣고 찧어서 덩어리를 없앤 후 완성되면 냉장 보관하거나 냉동 보관해 오래 두고 먹을 수 있다.

1인도 주문 가능한 편한 매장이다. 자리에 착석함과 동시에 우선 장단콩 볶은 것을 별미로 내어준다. 자전거를 저렇게 주차해 두기도 좋아 마음 편하게 식사를 주문하고 맛여행을 시작한다.



청국장 정식을 주문하면 각종 나물무침과 함께 10 찬이 자리 잡는다. 그중에서도 오늘 갓 만들어낸 순두부가 제공되는데 정말 구수한 첫 내음과 동시에 단 맛이 혀를 자극하며 입맛을 돋운다. 살짝 간장을 찍어내면 더욱 고소한 순두부의 맛을 즐길 수 있다. 애피타이저로 그만이다.
드디어 오늘의 하이라이트. 청국장이 나왔다. 일반적인 여느 식당에서 내놓는 청국장 콩의 양과는 비교도 할 수 없을 만큼 풍부한 청국장이다. 그렇다. 우선 비주얼부터 합격점이다.

그리고 코를 자극하는 청국장 냄새. 그러나 구수함 그 자체를 담아낸 내음이다. 전혀 비리거나 꼬숩지 않다. 걱정 마시라.

발효된 콩을 주재료로 한 음식이다 보니 특유의 깊고 진한 구수함을 자랑한다. 우리네 전통 발효식품의 특징 아니겠는가. 어찌 보면 크리미 하게까지 느껴지는 진한 국물. 부드러운 두부와 함께 어우러져 속을 든든하게 채워준다. 특유의 고릿하고 쿰쿰한 향은 살짝 매력 있다. 즐기다 보면 중독성까지 고려해야 한다. 왜냐면 장이 튼튼해지니까. ^^
각종 나물 무침에 함께 하는 두부, 그리고 청국장 국물에 담가 한 번 떠올리는 뽀얀 쌀밥을 상상해 보시라. 건강한 맛 그 자체다. 건강에 좋은 유산균과 영양소가 풍부한 메인 재료에 하얀 쌀밥과 각종 나물의 조화라니. 이 어찌 행복하지 아니한가!
제대로 된 건강식을 즐겨보고 싶다면 이 집을 추천한다. 한 번 가면 또 가게 되는 맛집 중의 맛집으로 추천한다.




돌아오는 리턴길. 파주로부터 출발하여 신사역까지 약 60km. 내가 조아라 하는 책문화와 산업의 메카라 불리는 파주 출판단지 길을 들러 잠시 책내음도 느껴보고 온다. 여의도 직선 주로를 지나 신사역에 안착. 이틀 동안 130킬로가 넘는 거리에 충분히 달궈진 내 엉덩이를 고려하여 지하철을 이용해 집으로 점프한다.
자 다음 브롬톤 라이딩 맛집은 어디일까?
(참고사항: 맛집 방문은 포스팅 당일을 의미하지 않습니다. 실제 방문일과 대략 2~3주 정도 텀이 있습니다. 광고지원도 없으며, 그 어떤 지원이나 홍보비를 받지 않는 개인적 견해를 담은 내용일 뿐이오니 오해 없으시길 바랍니다.)